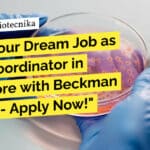
Lab Coordinator Jobs For Cell Biology, Immunology at Beckman Coulter Life Sciences "Land Your Dream Job as a Lab Coordinator in Bangalore with Beckman Coulter - Apply Now!"

Home Search
biology - search results
If you're not happy with the results, please do another search
Biology Jobs at Reliance Industries – PhD Apply For Research Scientist Role
Biology Jobs at Reliance Industries - PhD Apply For Research Scientist Role
Research Scientist
Posted Date: 22 Feb 2024
Function/Business Area: Research & Development
Location: Vadodara
Job Responsibilities:
...
Reliance Life Sciences Walk-In-Drive For MSc, MTech & BTech Biotech, Biochem & Microbiology
Reliance Life Sciences Walk-In-Drive For MSc, MTech & BTech Biotech, Biochem & Microbiology
Reliance Life Sciences
WE ARE HIRING!
-Navi Mumbai-
We welcome women returning to the workforce...
Reliance Life Sciences Jobs! BSc & MSc Biotech, Biochem & Microbiology Attend Walk-In
Reliance Life Sciences Jobs! BSc & MSc Biotech, Biochem & Microbiology Attend Walk-In
Reliance Life Sciences
WE ARE HIRING!
for Nashik and Navi Mumbai
Plasma
We welcome women returning...
Computational Biology Summer Research Programme 2024 at IMSc – Apply Online
Computational Biology Summer Research Programme 2024 at IMSc - Apply Online
The Institute of Mathematical Sciences
A national institute for research in the theoretical sciences
Summer Research...
JNCASR Project Oriented Biology Education (POBE) 2024 – Applications Open!
JNCASR POBE 2024 Applications - Project Oriented Biology Education
About POBE
As part of its Science Outreach Programme, Jawaharlal Nehru Centre for Advanced Scientific Research (JNCASR)...
Microbiology Job Opening at Presidency University – Life Sciences & Biotech Attend Walk-In
Microbiology Job Presidency University - Life Sciences & Biotech Attend Walk-In
Advertisement inviting applications for the position of a Junior Research Fellow in a Department...
Lab Coordinator Jobs For Cell Biology, Immunology at Beckman Coulter Life Sciences
Lab Coordinator Jobs For Cell Biology, Immunology at Beckman Coulter Life Sciences
Laboratory Coordinator (Contract)
Beckman Coulter Life Sciences
Location: Bangalore, Karnataka, India
Category: Other
Job ID: R1260594
Job Description...
CCMB Biology, Cell Biology Multiple Project Vacancies – Apply Online
CSIR-CCMB Biology Jobs 2024 - Life Sciences Candidates Apply Online
CSIR-CCMB Biology Jobs 2024 - Life Sciences Candidates Apply Online. Interested and eligible applicants can...
Exclusive Anthem Biosciences Recruitment – Job For MSc / MTech Biotech / Microbiology in...
Anthem Biosciences Biotech Job - MSc, MTech Apply
Welcome to Anthem BioSciences Job Posting
Anthem BioSciences is a leading biotechnology company dedicated to transforming lives by...
NCCS Pune Mol Bio, Genetics, Cell Biology Project Vacancies – Attend Walk-In-Interview
NCCS Pune Mol Bio Jobs, Genetics, Cell Biology Project Vacancies - Attend Walk-In-Interview
NCCS Pune Mol Bio Jobs, Genetics, Cell Biology Project Vacancies - Attend...
DIAGEO Quality Control Exec Job For Biotech, Biochem, Microbiology – Apply Online
DIAGEO Quality Control Exec Job For Biotech, Biochem, Microbiology - Apply Online
Senior Executive - Quality
Location: Guwahati, India
Employment Type: Full-time
Posted: Today
Job Requisition ID: JR1093453
Job Description...
Biotech Freshers Job Opening – Biochem & Microbiology Apply at Clarivate
Biotech Freshers Job Opening - Biochem & Microbiology Apply at Clarivate
Associate Content Editor - Biomedicine
We are looking for an Associate Content Editor to join our Biomedicine team in...
CDFD Agricultural Sciences, Molecular Biology Jobs With Up to Rs. 78,000 pm Pay –...
CDFD Molecular Biology Jobs With Up to Rs. 78,000 pm Pay - Agricultural Sciences Apply Online
CDFD Molecular Biology Jobs With Up to Rs. 78,000...
IISER Pune Summer Student Programme 2024 – Apply Online For Biology Projects
IISER Pune 2024 Summer Student Programme - Apply Online For Biology Projects
IISER Pune 2024 Summer Student Programme - Apply Online For Biology Projects. IISER...
IISER Pune PhD Biology, Biotech & Botany Research Job With Rs. 58,000 pm Pay...
IISER Pune PhD Biology, Biotech & Botany Research Job - Applications Invited
ADVERTISEMENT. NO.: 08/2024
The Indian Institute of Science Education and Research (IISER) Pune is...